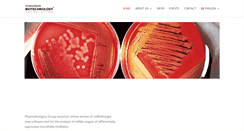
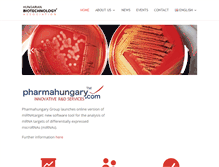

products2come.org
products2come.org
products2come | Turn your ideas into products
http://www.products2come.org/home
How to find a partner. How does partnering work. The first online partnering and technology transfer event for biotech, diagnostics, medtech, and pharma innovations. 19-20 May 2015, online. Successful debut: products2come enters the next round. Live online partnering meetings. Matchmaking has never been easier and more efficient. Register for products2come first. Upload your cooperation and product offers on the partnering platform. Find and contact potential cooperation partners easily. Products2come (p...
 products2come.org
products2come.org
Online Partnering | products2come
http://www.products2come.org/node/21
How to find a partner. How does partnering work. How to find a partner. How does partnering work. P2c partnering enables you to selectively arrange meetings prior to the p2c event. How does it work? Nothing could be simpler! Describe your company / organization / discoveries / products in your p2c profile. Specify when you have time for partnering meetings and when not. Find potential partners with the user-friendly search machine. Send them a request for a meeting in advance of the p2c partnering.
 szovetseg.lap.hu
szovetseg.lap.hu
Szövetség - Mezőgazdaság / erdészet. A legjobb válaszok profiktól.
http://szovetseg.lap.hu/mezogazdasag__erdeszet/16831471
Legyen a Startlap a kezdőlapom. Állam, közélet, politika. Magyar társadalom, közélet, politika. Http:/ szovetseg.lap.hu/. Agrárkutatás, fejlesztés, innováció. Ezt a linket add a Startlaphoz! Ezt a linket add a Startlaphoz! Fagazdasági Országos Szakmai Szövetség. Ezt a linket add a Startlaphoz! Ezt a linket add a Startlaphoz! Magyar Kertépítő és Fenntartó Vállalkozók Országos Szövetsége. Magyar Kertépítő és fenntartó Vállalkozók Országos Szövetsége. Ezt a linket add a Startlaphoz! Ön azt választotta, hogy...
 biofaba.org
biofaba.org
Welcome To Federation of Asian Biotech Associations
http://www.biofaba.org/Partners.aspx
 cebiotech.com
cebiotech.com
KCR SA - Companies -CEbiotech - be visible on tle BioBusiness market
http://cebiotech.com/Kcr-sa,4
Be visible on the BioBusiness market ISSN 2300-0228. 48 22 313 13 13. 48 22 313 13 14. Http:/ www.kcrcro.com/. To understand you better. To be the leading and most efficient Drug Development Company in Central and Eastern Europe. Our goal is to reinforce the positive image and excellent quality of clinical research in Central and Eastern Europe. We believe it will eventually contribute to improved healthcare for patients. While acknowledging our interdependence with clients, we believe t...
 cebiotech.com
cebiotech.com
Events / Reports -CEbiotech - be visible on tle BioBusiness market
http://cebiotech.com/Reports_9
Be visible on the BioBusiness market ISSN 2300-0228. The advancements in the food industry - Meat Workshop in Tallinn on 21 February 2013. PHARM Connect: Pharma and Biotech professionals of CEE getting together for further industry growth in the region. 2nd Annual Pharma Law Convention this time in Prague! 2nd edition of Pharma Law Convention organized . Czech Republic participation in Nanotech 2012 as the only producer of inorganic nano-fibers on the industrial scale. Central and Easter...
 cebiotech.com
cebiotech.com
Science -CEbiotech - be visible on tle BioBusiness market
http://cebiotech.com/Science_6
Be visible on the BioBusiness market ISSN 2300-0228. POTPAT Polish-Norwegian cooperation in potato protection. July 2016 is the final of Polish-Norwegian . Polyunsaturated fatty acids friends or foes? Retrotope is an American biotec. XXII Biotechnology Summer School - register till June 8th! XXII Biotechnology Summer School is coming . Welcome at the first European celebration of Women in Computing. Two incredible days, from 25 to 26th . The European Congress on Biotechnology. Retrotope ...
 cebiotech.com
cebiotech.com
Aurigon Life Science - Companies -CEbiotech - be visible on tle BioBusiness market
http://cebiotech.com/Aurigon-life-science,5
Be visible on the BioBusiness market ISSN 2300-0228. 49 (0)8158 2597 30. 49 (0)8158 2597 31. Is your full service CRO offering optimized and tailor-made solutions from candidate to marketed product. Our multidisciplinary team of experts based in Munich and in Budapest add value in all aspects of the non-clinical efficacy and safety testing of pharmaceuticals, chemicals and food ingredients and the bioanalytical support for all of these and clinical development. The most popular tags.
 cebiotech.com
cebiotech.com
Celther Polska Sp. z o.o. - Companies -CEbiotech - be visible on tle BioBusiness market
http://cebiotech.com/Celther-polska-sp-z-o-o,1
Be visible on the BioBusiness market ISSN 2300-0228. Celther Polska Sp. z o.o. 48 22 635 80 41. 48 22 635 76 26. Http:/ www.celtherpolska.com/. Is a young Polish biotech company, which was the first one in Poland to start works on the development of efficient and safe therapies concerning stem cells. Celther Poland is a great example of how successfully combine the potential of science and business to implement innovative scientific solutions into real industrial applications.
 ait-budapest.com
ait-budapest.com
AIT | Study Abroad for Computer Science and Software Engineering Majors
http://www.ait-budapest.com/faculty
Click here for details. AIT-Budapest is looking for a Program Assistant! Application for the 2017 Spring Semester is now open. Why Study Abroad in Hungary? Letter from the Founder. Tuition and Other Costs. Practical Issues and FAQ. To Send Prior To Arrival. How and when to apply? Application Form Spring Semester 2017. Application Form Fall Semester 2016. AIT at a glance. Responsible for coordinating AIT academic program and faculty. Structure and Dynamics of Complex Networks. The Weak Links at Springer.